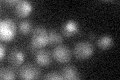
YOR386W

View description
DNA photolyase involved in photoreactivation, repairs pyrimidine dimers in the presence of visible light; induced by DNA damage; regulated by transcriptional repressor Rph1p
Localization:
Intensity:
Fold change:
Significance:
-
C’ GFP library in SD
nucleus19.45 -
N' NOP1pr-GFP in SD

mitochondria62.9402 -
N' TEF2pr-mCherry in SD

mitochondria49.4967 -
N' NATIVEpr-GFP in SD

nucleus16.5145 -
N' TEF2pr-VC and Cyto-VN in SD

#N/A0 -
C’ GFP library in SD+DTT

nucleus24.131.24No -
C’ GFP library in SD+H2O2

nucleus20.271.04No -
C’ GFP library in Starvation Media

nucleus44.332.27No -
C’ GFP library on the background of Pup2-DaMP

N/A -
C’ GFP library on the background of CCT mutant

N/A0N/AYes
